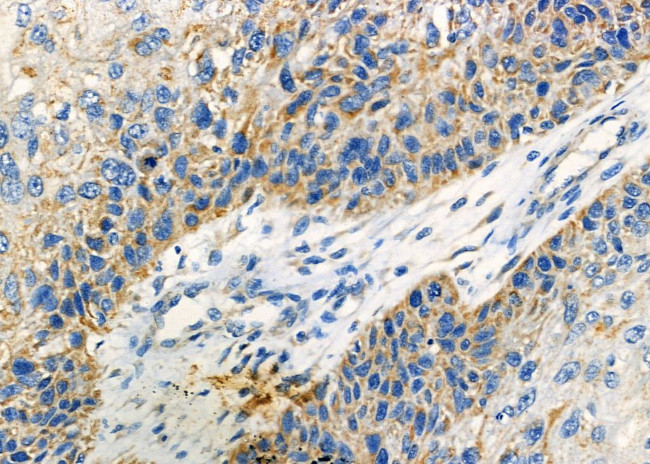
CRYBB2 Antibody in Immunohistochemistry (Paraffin) (IHC (P))

Search
Invitrogen
CRYBB2 Polyclonal Antibody
{{$productOrderCtrl.translations['antibody.pdp.commerceCard.promotion.promotions']}}
{{$productOrderCtrl.translations['antibody.pdp.commerceCard.promotion.viewpromo']}}
{{$productOrderCtrl.translations['antibody.pdp.commerceCard.promotion.promocode']}}: {{promo.promoCode}} {{promo.promoTitle}} {{promo.promoDescription}}. {{$productOrderCtrl.translations['antibody.pdp.commerceCard.promotion.learnmore']}}
图: 1 / 6
CRYBB2 Antibody (PA5-102805) in IHC (P)






Please note: We are reviewing Western blot images included in the antibody testing data in our catalog, including those provided by third parties. Unless expressly labeled or annotated as “raw-unedited”, Western blot images included in the antibody testing data in our catalog may have been edited, optimized or otherwise adjusted for presentation.
产品信息
PA5-102805
种属反应
宿主/亚型
分类
类型
抗原
偶联物
形式
浓度
规格
纯化类型
保存液
内含物
保存条件
运输条件
RRID
产品详细信息
Antibody detects endogenous levels of total CRYBB2.
靶标信息
Crystallins are separated into two classes: taxon-specific, or enzyme, and ubiquitous. The latter class constitutes the major proteins of vertebrate eye lens and maintains the transparency and refractive index of the lens. Since lens central fiber cells lose their nuclei during development, these crystallins are made and then retained throughout life, making them extremely stable proteins. Mammalian lens crystallins are divided into alpha, beta, and gamma families; beta and gamma crystallins are also considered as a superfamily. Alpha and beta families are further divided into acidic and basic groups. Seven protein regions exist in crystallins: four homologous motifs, a connecting peptide, and N- and C-terminal extensions. Beta-crystallins, the most heterogeneous, differ by the presence of the C-terminal extension (present in the basic group, none in the acidic group). Beta-crystallins form aggregates of different sizes and are able to self-associate to form dimers or to form heterodimers with other beta-crystallins. This gene, a beta basic group member, is part of a gene cluster with beta-A4, beta-B1, and beta-B3. A chain-terminating mutation was found to cause type 2 cerulean cataracts.
仅用于科研。不用于诊断过程。未经明确授权不得转售。
篇参考文献 (0)
生物信息学
蛋白别名: Beta crystallin B2; Beta crystallin Bp; Beta-B2 crystallin; Beta-crystallin B2; Beta-crystallin Bp; CCA 2; CRYB B2; CRYBB 2; OTTHUMP00000198622; R.norvegicus CRYBB2 gene (crystallin, beta B2)
基因别名: Cryb-2; CRYB2; CRYB2A; CRYBB2
UniProt ID: (Mouse) P62696, (Rat) P62697
Entrez Gene ID: (Mouse) 12961, (Rat) 25422